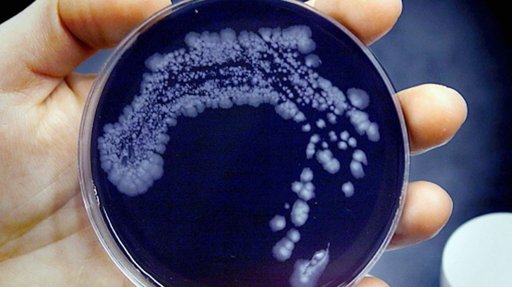
Bactéria 'Legionella' Detetada em Lar de Idosos em Lagos

A carência de professores no início do ano letivo continua a ser um problema crítico, com números díspares entre o Governo e os sindicatos.
A questão é complexa, envolvendo desequilíbrios geográficos e a necessidade de uma valorização estrutural da carreira docente para garantir a cobertura de todas as vagas e a qualidade do ensino público.